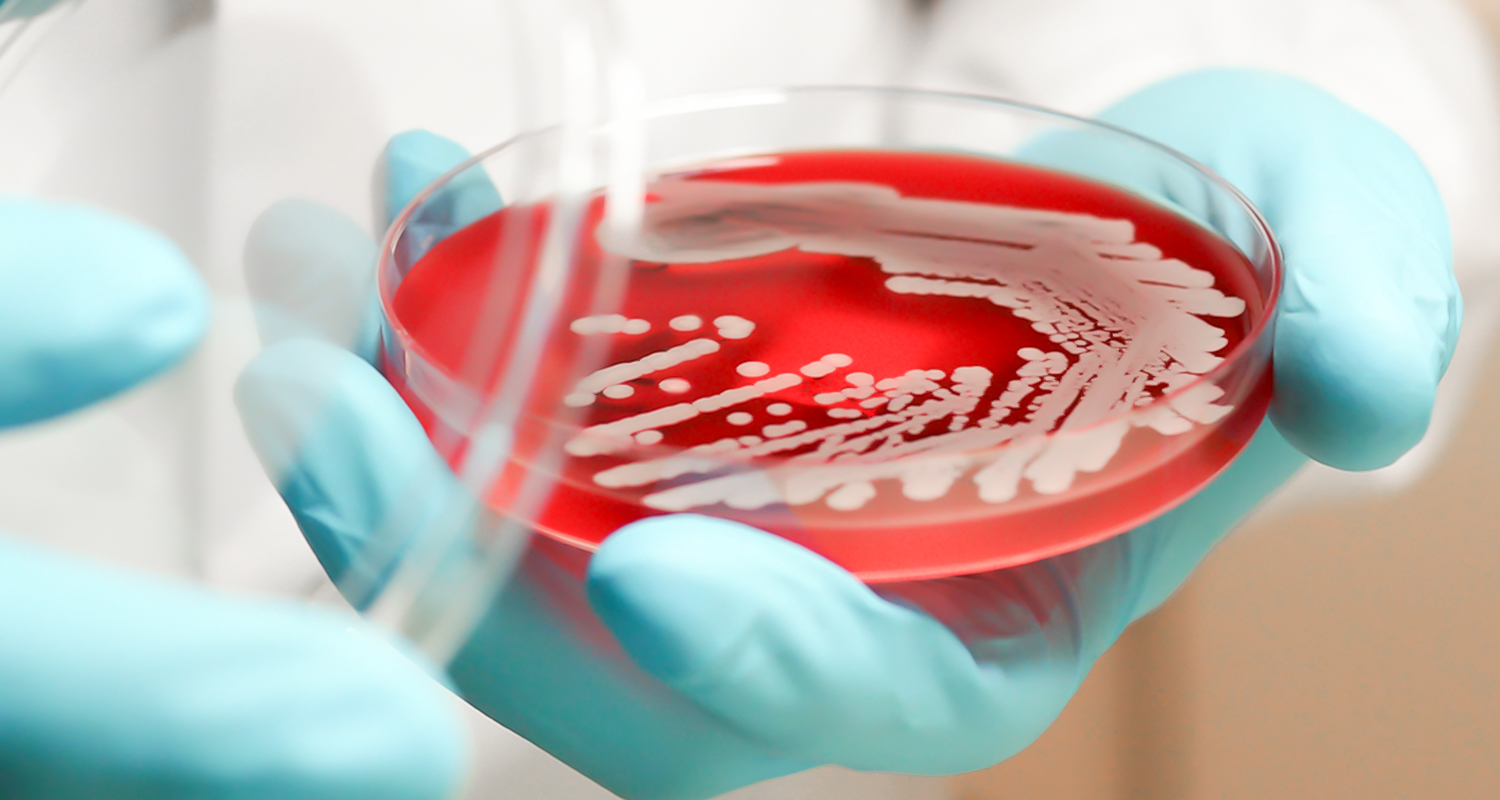
موجودات هوازی

موتور القایی جریان متناوب
موتور القایی جریان متناوب به انگلسی موتور القایی جریان متناوب در انگلیسی معادل (AC induction motor) می باشد. AC مخفف (Alternating Current) و به معنای جریان متناوب می باشد. موتور القایی جریان متناوب چیست؟ این ادامه مطلب
موتور دور متغیر
موتور دور متغیر به انگلیسی موتور دور متغیر در انگلیسی معادل (adjustable speed motor) می باشد. موتور دور متغیر چیست؟ اصطلاح موتور دور متغیر به معنای الکتروموتوری است که سرعت آن قابل تنظیم می باشد. ادامه مطلب
موتور هوا خنک
موتور هوا خنک به انگلیسی موتور هوا خنک در انگلیسی معادل (air cooled motor) می باشد. موتور هوا خنک چیست؟ موتور هوا خنک موتوری است که با جریان هوای آزاد خنک می گردد. برای دسترسی ادامه مطلب
موجودات هوازی
موجودات هوازی به انگلیسی موجودات هوازی در انگلیسی معادل (aerobic organisms) می باشد. موجودات هوازی چیست؟ اصطلاح موجودات هوازی یا اندامگان هوازی به معنای موجوداتی می باشند که در محیط حاوی اکسیژن می توانند رشد ادامه مطلب
مولد سرمایش جذبی
مولد سرمایش جذبی به انگلیسی مولد سرمایش جذبی در انگلیسی معادل (absorption liquid chiller) می باشد. مولد سرمایش جذبی چیست؟ مولد سرمایش جذبی دستگاهی است که در آن تبخیر آب در فشار بسیار پایین موجب ادامه مطلب
موم چسبناک
موم چسبناک به انگلیسی موم چسبناک در انگلیسی معادل (adhesive wax) می باشد. موم چسبناک چیست؟ موم چسبناک یک نوع چسب نرم است که چسبندگی بالایی دارد و قطعات را با فشار کمی می چسباند. ادامه مطلب
نرخ مطلق تصفیه
نرخ مطلق تصفیه به انگلیسی نرخ مطلق تصفیه در انگلیسی معادل (absolute filtration rating) می باشد. نرخ مطلق تصفیه چیست؟ نرخ مطلق تصفیه قطر بزرگترین ذره کروی که از یک فیلتر در شرایط ویژه آزمایش ادامه مطلب
نسبت هوا به سوخت
نسبت هوا به سوخت به انگلیسی نسبت هوا به سوخت در انگلیسی معادل (air-fuel ratio) می باشد. نسبت هوا به سوخت چیست؟ اصطلاح نسبت هوا به سوخت به معنای نسبت وزنی هوا به سوخت برای ادامه مطلب
نفوذ هوا
نفوذ هوا به انگلیسی نفوذ هوا در انگلیسی معادل (air infiltration) می باشد. نفوذ هوا چیست؟ نفوذ هوا به معنای نشت و نفوذ هوا از فضای بیرونی به فضای داخل بر اثر فشار هوای بیرون ادامه مطلب
نم جذب شده
نم جذب شده به انگلیسی نم جذب شده در انگلیسی معادل کلمه (absorbed moisture) می باشد. نم جذب شده چیست؟ نم جذب شده رطوبتی است كه به حالت جذب وارد يك ماده جامد شده و ادامه مطلب